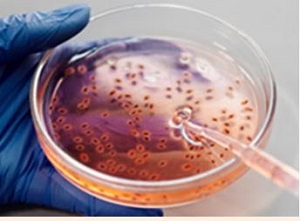

انتشارات الزویر Elsevier دسترسی رایگان به محتوا و منابع را از طریق مرکز اطلاعات آبله میمونی که به تازگی راهاندازی شده را برای تسریع مبارزه با این بیماری ویروسی برقرار میکند. این مرکز اطلاعات آنلاین، دسترسی رایگان متخصصان مراقبتهای بهداشتی، محققان پزشکی و عموم مردم به آخرین اطلاعات پزشکی و علمی از سراسر محتوای تحقیقاتی جهانی، پلتفرمها و منابع بالینی الزویر را فراهم میکند.
نشانی مرکز اطلاعات آبله میمونی (https://www.elsevier.com/connect/monkeypox-information-center)
راهاندازی این مرکز اطلاعات بخشی از تعهد الزویر برای حمایت از جوامع تحقیقاتی و مراقبتهای بهداشتی در تلاشهایشان برای رسیدگی به شرایط اضطراری بهداشت عمومی است. این مرکز به طور مداوم به روز میشود و دسترسی رایگان به تحقیقات مرتبط و اطلاعات بالینی در مورد ویروس آبله میمون از ژورنالهای علمی و پزشکی الزویر و منابع بالینی را برای متخصصان مراقبتهای بهداشتی فراهم میکند. این اطلاعات پژوهشی و بالینی به صورت رایگان از پلتفرمهای الزویر در دسترس خواهد بود و با سازمان بهداشت جهانی *(WHO)* نیز به اشتراک گذاشته خواهد شد.
علاوه بر این، تا زمانی که وضعیت اضطراری بهداشت عمومی آبله میمونی ادامه دارد، این شرکت مقالات ژورنالهای مرتبط با آبله میمونی را به *PubMed Central*، آرشیو ژورنال ها و تحقیقات زیستپزشکی و علوم زیستی به منظور دسترسی و مطالعه رایگان پژوهشگران ارائه خواهد کرد.
